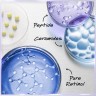
Kiehl’s Retinol Skin-Renewing Daily Micro-Dose Serum  Обновляющая кожу ежедневная микродозная сыворотка с ретинолом

Kiehl’s Retinol Skin-Renewing Daily Micro-Dose Serum Обновляющая кожу ежедневная микродозная сыворотка с ретинолом
Kiehl’s Retinol Skin-Renewing Daily Micro-Dose Serum Обновляющая кожу ежедневная микродозная сыворотка с ретинолом
Бренд:
Kiehl’sтип кожи: зрелая кожа
Сфера применения: Лицо
Характеристики
Вес отправления:
150 г
Тип товара:
Антивозрастная сыворотка
Размер:
50 ml, 30 ml
Бренд:
Kiehl’s
Категории
✔ Бесплатная доставка Пункт выдачи САНКТ-ПЕТЕРБУРГ, Лиговский проспект 74, Самовывоз
Избранное
Сравнение
Описание
lt;stronggt;Сыворотка с ретинолом для любой кожиlt;/stronggt;Сыворотка Kiehl#39;s Retinol Skin-Renewing Daily Micro-Dose Serum усердно работает, чтобы вернуть молодое сияние и упругость вашей коже. Антивозрастной уход содержит микродозированный ретинол, который поддерживает естественные процессы регенерации кожи и способствует выработке коллагена. Есть также пептиды: с одной стороны, для структурной регенерации, с другой стороны, чтобы помочь коже впитывать ретинол. Керамиды улучшают уникальное сочетание активных ингредиентов: они помогают сделать кожу упругой, регенерируют липиды кожного барьера и повышают толерантность к ретинолу. Результат: морщины сокращаются, поры очищаются, кожа становится более гладкой и упругой, а при постоянном использовании в целом выглядит более молодой уже через несколько недель. Сыворотка с ретинолом хорошо переносится, поэтому каждый тип кожи может извлечь пользу из этого эффективного антивозрастного ухода.
\u003Cul style=\quot;list-style-type:square\quot;\u003E\u003Cli\u003ENПосле очищения нанесите сыворотку с ретинолом на все лицо, включая область под глазами и область, склонную к гусиным лапкам. Избегайте контакта с глазами и веками. \ u003C / li \ u003E \ u003Cli \ u003ERRetinol Skin-Renewing Daily Micro-Dose Serum подходит для утреннего или вечернего использования. такие как Корректор темных пятен, Сыворотка с витамином С, Сыворотка для укрепления кожи или Сыворотка для увеличения объема кожи. для лица с SPF 50.\u003C/li\u003E\u003C/ul\u003E
Характеристики
Вес отправления | 150 г |
Тип товара | Антивозрастная сыворотка |
Размер | 50 ml, 30 ml |
Бренд | Kiehl’s |